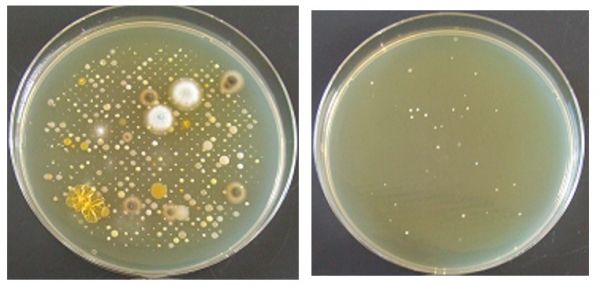

ソーシャル・アップデート・カンパニー、みんな電力株式会社(所在地:東京都世田谷区 代表取締役:大石英司、以下「みんな電力」)は、安心で安全な暮らしを実現する室内の空気環境づくりを目指し、空気環境対策事業「みんなエアー」を2020年3月24日(火)に開始します。空気中に含まれる菌類を可視化することで、オフィスや店舗の空気環境を把握し、さまざまな対策を行なえるようサポートをします。
1. 背景
2016年より、みんな電力は法人および個人向けに電気の生産者がわかる「顔の見える電力(TM)」を供給し、FIT電気および再生可能エネルギーの利用を推進してきました。
安心で安全な暮らしには、電気だけではなく、衛生的な空気が不可欠です。室内の空気中にはさまざまな物質が混合しておりPM2.5などの有害物質やインフルエンザウイルス、ブドウ球菌などといった、人体に影響を及ぼす可能性のある物質も多く含まれています。室内の空気環境に社会的関心が高まっているいま、空気中の菌類を可視化して対策を提案することで、持続可能な社会づくりに貢献していきます。
2. サービス概要
サービス名称:みんなエアー
提供メニュー:
(1) 浮遊菌検査
オフィスや店舗内の空気を吸引し、浮遊菌を採取。人体に影響を及ぼすといわれる19種類※の浮遊菌数を調査します。
※ブドウ球菌、糸状様真菌、ミクロコッカス など
(2) 検査結果を基にした最適なソリューション提供
第三者研究機関の実証試験により「実空間における浮遊菌減少が89.6%」と証明された紫外線殺菌照射装置を用い、空気環境の改善につなげます。
サイトURL:https://minnaair.com
<浮遊菌検査を行う様子>
1. 背景
2016年より、みんな電力は法人および個人向けに電気の生産者がわかる「顔の見える電力(TM)」を供給し、FIT電気および再生可能エネルギーの利用を推進してきました。
安心で安全な暮らしには、電気だけではなく、衛生的な空気が不可欠です。室内の空気中にはさまざまな物質が混合しておりPM2.5などの有害物質やインフルエンザウイルス、ブドウ球菌などといった、人体に影響を及ぼす可能性のある物質も多く含まれています。室内の空気環境に社会的関心が高まっているいま、空気中の菌類を可視化して対策を提案することで、持続可能な社会づくりに貢献していきます。
2. サービス概要
サービス名称:みんなエアー
提供メニュー:
(1) 浮遊菌検査
オフィスや店舗内の空気を吸引し、浮遊菌を採取。人体に影響を及ぼすといわれる19種類※の浮遊菌数を調査します。
※ブドウ球菌、糸状様真菌、ミクロコッカス など
(2) 検査結果を基にした最適なソリューション提供
第三者研究機関の実証試験により「実空間における浮遊菌減少が89.6%」と証明された紫外線殺菌照射装置を用い、空気環境の改善につなげます。
サイトURL:https://minnaair.com
<浮遊菌検査を行う様子>

<採取された浮遊菌>
3. 今後の展開
本サービスのオフィスや店舗への導入を推進するとともに、検査可能な微生物を増やし、衛生的で快適な空気環境づくりに貢献していきます。
また、当社はソーシャル・アップデート・カンパニーとして、電気だけでなく「顔の見えるライフスタイル」の実現に向けてさまざまな業界と連携し、透明性と納得感をお届けする事業開発を進めていきます。
4. 会社概要
会社名 :みんな電力株式会社
会社概要:大手印刷会社で新規事業を担当していた代表取締役の大石が、再生エネルギー事業会社として2011年に設立。2016年に「顔の見える電力TM?」として電気の生産者と生活者をつなぐサービスを開始。
所在地 : 東京都世田谷区三軒茶屋2-11-22 サンタワーズセンタービル8F
資本金 : 1億円(資本準備金8億3,420万円)
設 立 : 2011 年 5 月
代表者 : 代表取締役 大石 英司
URL : http://minden.co.jp
5. 本件に関する問い合わせ先
みんな電力株式会社 広報担当 佐藤、中村、姫井
E-mail :pr@minden.co.jp
TEL : 03-6805-2228
本サービスのオフィスや店舗への導入を推進するとともに、検査可能な微生物を増やし、衛生的で快適な空気環境づくりに貢献していきます。
また、当社はソーシャル・アップデート・カンパニーとして、電気だけでなく「顔の見えるライフスタイル」の実現に向けてさまざまな業界と連携し、透明性と納得感をお届けする事業開発を進めていきます。
4. 会社概要
会社名 :みんな電力株式会社
会社概要:大手印刷会社で新規事業を担当していた代表取締役の大石が、再生エネルギー事業会社として2011年に設立。2016年に「顔の見える電力TM?」として電気の生産者と生活者をつなぐサービスを開始。
所在地 : 東京都世田谷区三軒茶屋2-11-22 サンタワーズセンタービル8F
資本金 : 1億円(資本準備金8億3,420万円)
設 立 : 2011 年 5 月
代表者 : 代表取締役 大石 英司
URL : http://minden.co.jp
5. 本件に関する問い合わせ先
みんな電力株式会社 広報担当 佐藤、中村、姫井
E-mail :pr@minden.co.jp
TEL : 03-6805-2228




